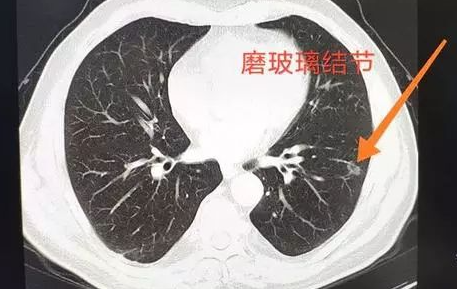
磨玻璃结节

肺的磨玻璃结节就是指的在肺中有一些密度比较低的像磨渣样的玻璃,或者类似云雾一样的、小片状的、比较局限的结节,或者有时像一团小棉花一样的结节。由于它的密度相对来说不一样,密度比较低,和实性结节比没有那么高的密度,所以称之为磨玻璃结节。
磨玻璃结节也有单发的、多发的,原因也比较多,有的是原来病灶的激化导致,也有的是炎症、真菌感染导致,也有可能是特殊的病原体导致,当然这里边的结节可能是恶性肿瘤。单纯的结节,尤其是孤立的结节,还是要小心,要动态观察,特别是没有症状固定的结节就要随诊。
有什么办法能够改善磨玻璃结节?
1、采取积极运动的生活方式
成年人应该保证每周至少150分钟的中等强度运动或者至少75分钟的高强度运动,更好的就是中等和高强度俩种活动相当量的组合,等价的运动量在一周分几次展开。
2、健康饮食,以植物类食物为重点
选择食物和饮料的数量可以帮助达到和维持健康体重;限制加工肉类和红色肉类的摄入;每天吃至少2.5杯的蔬菜水果;选择全谷类食物来代替精制谷物。
海鲜
肺磨玻璃结节需要忌嘴吗?很多人说海鲜不能吃,鸡不能吃,鸡蛋不能吃!”对于西医来说,磨玻璃结节患者没有特别禁忌的食物,只要注意营养均衡容易消化即可,无论是海鲜还是江鲜,如果喜欢吃,就吃一些,很多美国人基本都不吃淡水鱼,他们只吃海鱼,也没出现肿瘤患者预后特别差的情况。千万不要被一些没有根据的“经验”,把自己的生活封闭在狭小的空间。

酒精
饮酒会增加癌症风险吗?是的。饮酒会增加口腔癌,咽癌,喉癌,食管癌,肝癌,肠癌,乳腺癌的风险。饮酒的人应该限制饮酒量,男性每天不能多于2杯,女性每天不能多于1杯。一杯酒被定义为330ml的啤酒,140ml的白酒。饮酒与吸烟同时存在增加癌症的风险远远大于单一的饮酒和吸烟对癌症风险的影响。女性每周经常喝几杯酒与增加乳腺癌风险有关。